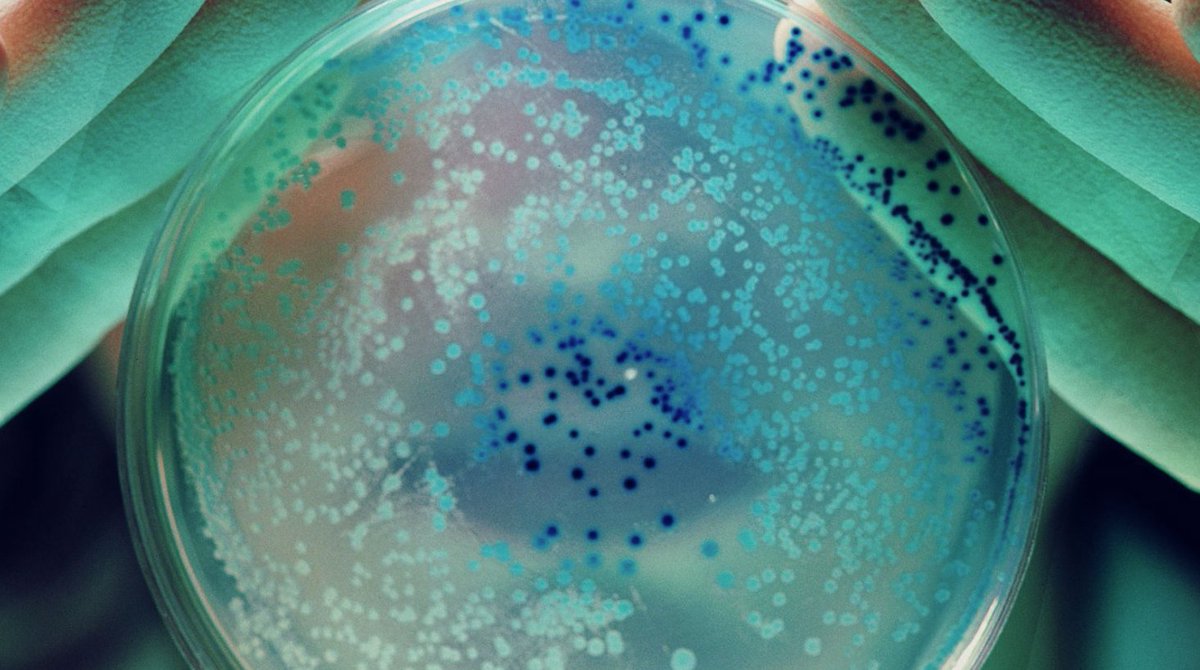

Enrico Orsi
@enricoorsi
Bolognese🇮🇹 in CPH🇩🇰| Metabolic Engineering | Synthetic Biology | @MSCActions postdoc @LabNikel @DTUBiosustain 🧬🦠 formerly @WeTheBarEvenLab🇩🇪 @WUR🇳🇱
ID: 268771984
https://scholar.google.com/citations?user=apnOuPkAAAAJ&hl=en 19-03-2011 12:44:18
455 Tweet
613 Takipçi
420 Takip Edilen


Our years of work on nitrogenase assembly paid off! So proud of this paper, which demonstrates the heterologous expression of an active nitrogenase. Thanks to everybody involved for a great team effort! Nature Catalysis, Ribbe Hu Labs, UCI Charlie Dunlop School of Biological Sciences, UCI Chemistry doi.org/10.1038/s41929…


beta.ecrcentral.org/resources/mate… Thanks to the new website of Adrian Jinich I got to know about the existence of this database. Very useful resource with a lot of links useful for career development!

An enzymatic cascade for high-yield and stereoselective synthesis of 4-fluoro-L-threonine led by Alberto De Maria & Manuel Nieto-Domínguez Nikel SEM Group DTU Biosustain Chem Catalysis #Fluorine #Biocatalysis #Green #Chemistry Read for free here 👇 authors.elsevier.com/a/1jxL89URZ7rP…


Novel enzyme starts with promiscuity. Excited to share our study that shows how #evolution recruits a single enzyme for multiple purposes, showcasing the plasticity and flexibility of #metabolism. Huge thanks to my colleagues at SYBORG & Max Planck Institute for Terrestrial Microbiology! rdcu.be/dXaqU



I am looking for a post-doc researcher to work on my #ERC project EcoMEMO Università di Bologna. The position is for 2 years full time starting latest in March 2025, with lots of field and labwork. To apply visit the link bandi.unibo.it/ricerca/assegn… (in italian and english). More info ⬇️




Check this #overview from our Nikel SEM Group to see what we have been up to during this 2024!👇


Computation-aided designs enable developing auxotrophic #metabolic #sensors for wide-range glyoxylate and glycolate detection—spearheaded by Enrico Orsi w/a choral assembly of cool collaborators Nikel SEM Group Nature Communications #SynBio #OpenAccess nature.com/articles/s4146…


Streamlined and efficient genome editing in #Cupriavidus necator H16 using an optimised SIBR-Cas system—spearheaded by @dellavallesimo & Enrico Orsi & led by Costas Patinios + Wei Huang Trends in Biotechnology #SynBio sciencedirect.com/science/articl…